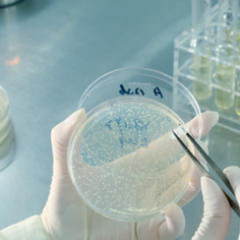

哺乳动物细胞表达服务
哺乳动物细胞自身具备蛋白折叠和翻译后修饰功能,其表达的重组蛋白在分子结构、理化性质和生物学功能方面最接近于天然的高等生物蛋白质分子,更有可能获得与天然分子相同的生物活性。哺乳动物细胞表达可实现重组蛋白尤其是膜蛋白以及重组抗体的高效表达。佰翱得团队具丰富的哺乳动物细胞蛋白表达经验,累计为客户提供了3000+批次的蛋白表达服务。
服务内容
| 瞬时转染表达 | Expi293F, Expi293F GnTI-,HEK293S GnTI- | PEI瞬转,高效表达膜蛋白,同时可提供Thermo 商业化转染体系 |
| 病毒感染表达 | Expi293F, Expi293F GnTI-,HEK293S GnTI- | pEGBacmam载体,可选常规病毒接种和病毒浓缩接种 |
| 重组抗体表达 | ExpiCHO-S | Thermo 商业化转染体系, 表达量可达g/L级别 |
| 稳转细胞构建 | 传统G418筛选和PiggyBac稳转系统 | 2-3个月获得稳转细胞 |
服务流程
-

![]()
质粒小提3天
-

![]()
10ml表达小试5天
-

![]()
质粒大提并验证2天
-

![]()
大量表达2-3天

蛋白表达
蛋白表达

